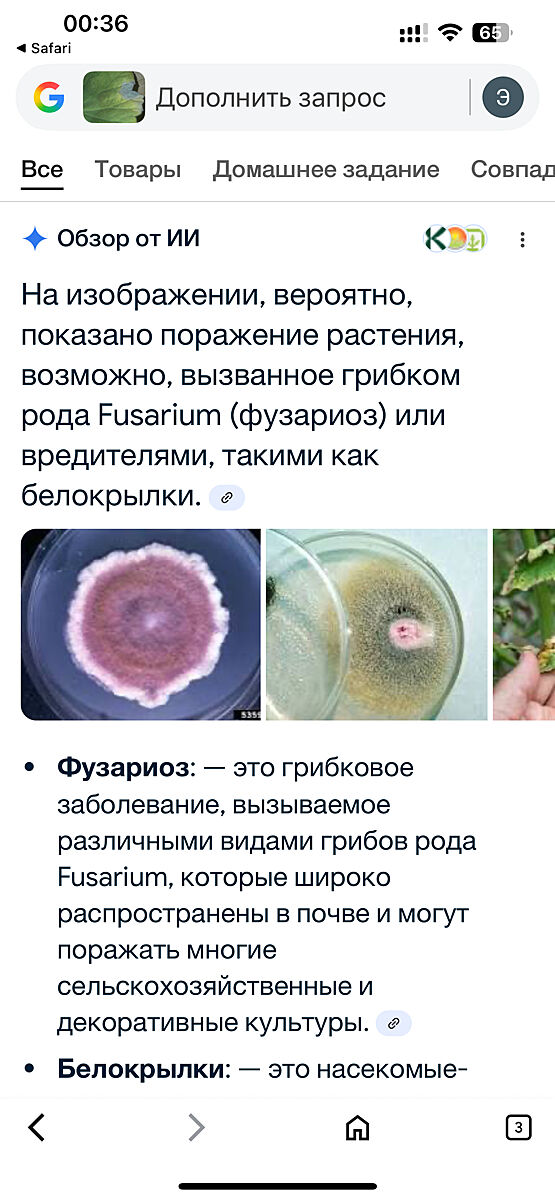

Умничка-помощничка• 13 августа 2025
Чем помочь герани?
Мама пожаловалась, что ее герань вот так теряет листики. Начинают желтеть, желтеют и отпдадают.
Что это и чем помочь в домашних условиях?
Что это и чем помочь в домашних условиях?
ПриснитсяЖЕ• 13 августа 2025
вариантов всего два - либо грибок (обработка фунгицидом), либо насекомые (обработка инсектицидом)
мне кажется, что первое
мне кажется, что первое
 2
2
Г@Л@В@ломка• 13 августа 2025
Ответ дляПриснитсяЖЕ
вариантов всего два - либо грибок (обработка фунгицидом), либо насекомые (обработка инсектицидом)
мне кажется, что первое
мне кажется, что первое
Да, скорее всего грибок. Оборвать все пораженные листочки, землю тоже лучше заменить. Обработать фунгицидом. Если земля не будет заменена,то и ее тщательно обработать.
Мнения, изложенные в теме, передают взгляды авторов и не отражают позицию Kidstaff
Тема закрыта
Похожие темы:
Назад Комментарии к ответу